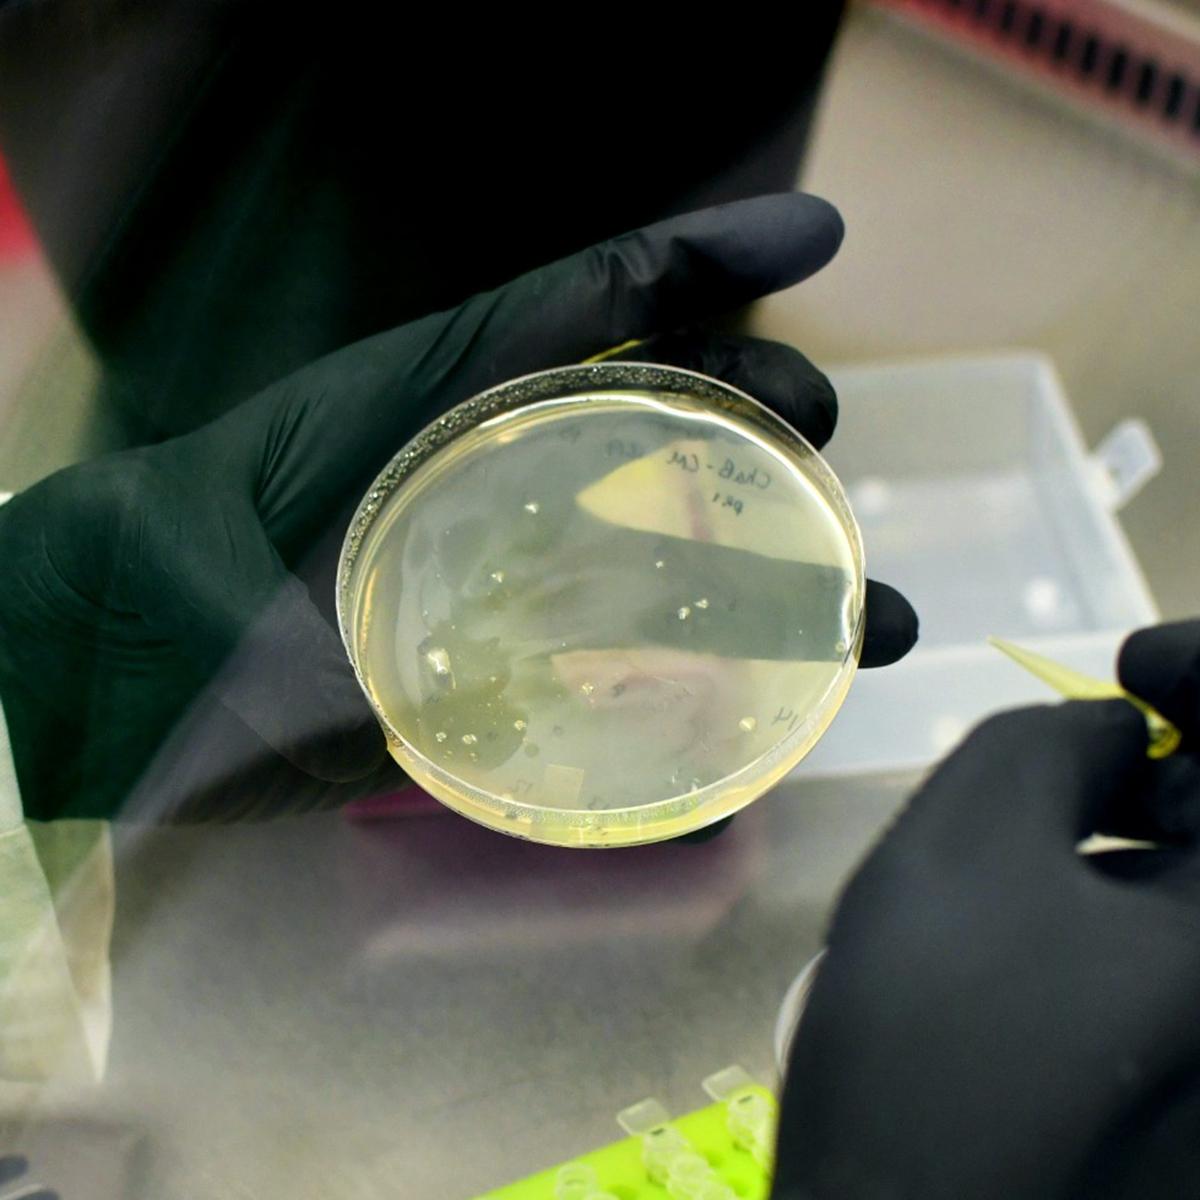
Researcher holding a glass container

Antimicrobial Resistance Research
University of Guelph researchers tackle antimicrobial resistance (AMR) through a One Health approach, collaborating across disciplines and with global partners to address interconnected health challenges affecting humans, animals, plants and the environment. Their work focuses on preventing infections, limiting resistance and advancing strategies that strengthen global health resilience.
Themes
U of G researchers tackle antimicrobial resistance through Research and Innovation, Leadership, Stewardship and Infection Prevention and Control, developing solutions, guiding coordinated responses, promoting responsible antimicrobial use and strengthening strategies to prevent infections across human, animal and environmental health.
Research and Innovation
Research and innovation are vital for tackling antimicrobial resistance. U of G researchers advance understanding and develop solutions, driving significant progress in preventing infections and combating AMR on a global scale.

Leadership
U of G researchers provide leadership in antimicrobial resistance, fostering collaboration and coordination across disciplines. Their expertise and commitment help shape effective, impactful strategies to address AMR globally.

Stewardship
Stewardship involves responsible and judicious use of antimicrobials. Researchers at the U of G aim to promote practices that prevent the misuse and overuse of antibiotics and other antimicrobials, preserving their effectiveness.

Infection Prevention and Control (IPC)
IPC measures help minimize the transmission of infections, reducing the need for antimicrobials. U of G researchers focus on strategies to prevent infections and enhance control measures.
AMR Articles

U of G Research Investigates Efflux Pumps to Combat Antimicrobial Resistance
Date: November 15, 2024
Researcher: Georgina Cox

U of G Researcher Involved in Global Collaboration for Antimicrobial Resistance
Date: November 22, 2023
Researcher: Scott Weese

U of G Enhancing AMR Surveillance with a New Platform
Date: November 21, 2023
Researcher: Nicole Ricker